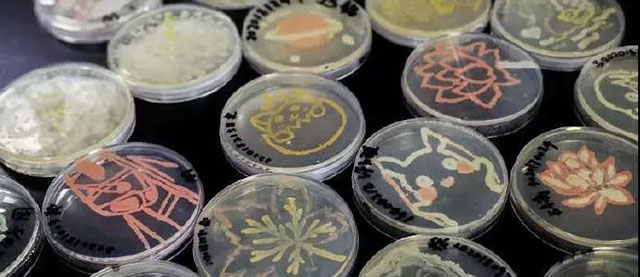

【一周检讯】检验科被托管,检验人才培养怎么办?
检验科被托管,检验人才培养怎么办?
检验科被托管,托管公司出于人力成本的考虑,通常不会投入大量资金进行人员的教育培训和外出进修;也不太会重视科研,鼓励科研的更是少之又少。这不仅影响检验人的个人发展,长此以往必然影响检验学科的发展。
近日济阳县中医院的这份两科室合作共建项目的招标内容让我们重新看到了医院方对检验科托管后人才问题的重视态度!
采购要求第六七点明确提及人员培养方面:合作单位需要为医院提供完善的人才培养计划,包含但不限于如新项目培训、各类学术会议、进修等等。(来源:体外诊断联盟)

细菌画成的皮卡丘你见过吗?
中国药科大学学子用葡萄球菌、大肠杆菌等菌落为“翰墨颜料”,在营养琼脂培养基平板中绘制好图案,然后放入37℃恒温培养箱中培养。三天后,图案就出来了。(来源:医学界)
最新全球癌症负担报告发布
《美国医学会杂志》的肿瘤学子刊发布最新全球癌症负担报告。结果显示,2006~2016年这十年间,全球癌症病例又增加28%。仅2016年,全球就有1720万癌症病例,导致890万人死亡。肺癌是全球发病率、死亡率最高的癌症。10年间,肺癌病例增加28%,结直肠癌发病率增加34%,前列腺癌增长了40%。
报告列出了威胁中国人的癌症,发病率前五的是:肺癌、肝癌、胃癌、结直肠癌、乳腺癌;死亡率前五的是:肺癌、肝癌、胃癌、食管癌、结直肠癌。
《中国乳腺癌患者BRCA1/2基因检测与临床应用专家共识》(2018年版)发布
中国乳腺癌患者BRCA基因检测与临床应用专家共识是首个针对中国人群乳腺癌BRCA检测专家共识,随着相关研究的进展,会定期进行更新。
目前中国人群的BRCA突变相关研究较少,部分内容目前共识尚无法给出明确建议,需要进一步的研究,同时大众对于乳腺癌的BRCA检测的重要性认识不足,需要医生和患者共同努力。在国外数据分析的基础之上,构建我国大样本 BRCA基因突变数据库并进行规范解读,可以指导与规范BRCA基因检测在我国的临床应用,改善相应患者的治疗策略,提高高危人群的筛查和预防水平。
相信随着中国BRCA基因检测规范化与可及性的提高,中国人群特有的BRCA基因突变数据库的逐步建立以及BRCA基因突变的致病性理解加深,我们对BRCA基因检测结果的判定会越来越准确,对携带BRCA突变乳腺癌患者的诊疗水平会不断提升,对携带BRCA突变人群的遗传咨询及肿瘤风险管理能力逐渐提高,从而实现从精准治疗走向精准预防,防病于未治。(来源:中国癌症杂志)
全球首个肝硬化早诊试剂盒年底有望大规模应用
近日,首都医科大学附属北京佑安医院党委副书记、院长金荣华做客北京城市广播“市民对话一把手·市属医院院长”系列节目时透露,佑安医院研发的全球首个应用于肝硬化早期临床诊断试剂盒GP73试剂盒,常规采集静脉血,只需70分钟即可确诊是否患有肝硬化。
目前,这一全球首个应用于肝硬化早期临床诊断试剂盒,已取得海南省药监局的体外诊断试剂注册证,并与众多大型医院达成合作意向,有望今年底在全国各医院进行大规模应用。 (来源:中国体外诊断网)

倒计时3天!第七届东方检验医学学术会议
由上海市医学会、上海市医学会检验医学分会主办的“第七届东方检验医学学术会议”将于2018年12月6-8日在上海国际会议中心拉开帷幕。
会议涵盖临床血液、体液学、临床微生物学、临床生化和质谱、新技术和自动化、实验室管理与POCT、临床免疫学、流式和细胞分析以及分子诊断论坛,邀请国内外基础、临床和检验领域著名专家学者,以大会报告、专题演讲、青年英文交流的方式,聚焦检验新技术、新观点,就医学领域共同关心的大数据、智慧医疗、生物信息分析、转化研究前沿进展以及医改焦点和热点问题展开讨论。

中国老年医学会检验医学分会代谢与肾脏病学研讨会召开
中国老年医学会检验医学分会代谢与肾脏病学研讨会暨多中心临床研究路演在郑州召开。
会议邀请多位老年疾病领域的专家进行了专题的讲座,并首次尝试以路演的形式介绍正在进行或拟进行的多中心合作项目,希望通过此次交流促进中国老年医学代谢与肾脏相关疾病的进展。


